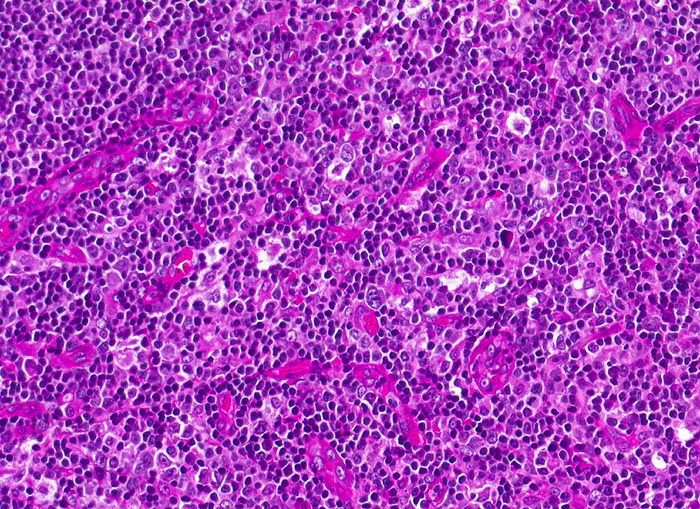

PathoPic – image database / PathoPic ID 4019 - infektiöse Mononukleose: bunte Pulpahyperplasie
de
Diagnose
infektiöse Mononukleose: bunte Pulpahyperplasie
Diagnose Gruppe
Entzündung infektiös
Topographie
Tonsille
Topographie Gruppe
Lymphatische Gewebe, KM, Milz
Beschreibung
Aktivierung der T-Lymphozyten-Areale (Virusantigen-induzierte Aktivierung der spezifischen antiviralen T-Zell-Antwort): Verbreiterung der interfollikulären T-Zone, auffallende Vermehrung hochendothelialer postkapillärer Venolen mit gesteigerter Lymphozyten-Rezirkulation, stimulierte T-Lymphozyten (grösser als normale Lymphozyten), T-Immunoblasten (zentraler Nukleolus). Insgesamt ein buntes Zellbild.
Klinik
Tonsillektomie bei einem Studenten mit Angina, Lymphknotenschwellungen und einer Lymphozytose im Blut.
Bilder Typ
Histologie
Vergrösserung
200
Alter
16
Geschlecht
männlich
Datum
Ersteintrag: 28.09.2002
Update: 04.02.2024